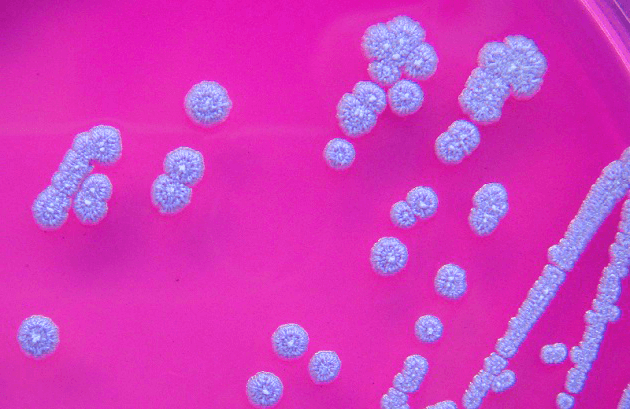
Bệnh Whitmore (vi khuẩn ăn thịt người) hiện chưa có vắc xin và dễ tử vong nếu không được điều trị kịp thời

Chiều 11/9, Sở Y tế Thanh Hóa cho biết, đã phát hiện bệnh nhân mắc Whitmore tại địa bàn. Đây là ca bệnh đầu tiên ở Thanh Hoá trong năm 2023.
Bệnh nhân là một cô bé 15 tuổi, ở xã Tiên Trang (Quảng Xương) có kết quả dương tính với vi khuẩn Brukholderia pseudomallei, được điều trị tại Bệnh viện Nhi Thanh Hóa.
Theo điều tra ban đầu của Trung tâm y tế huyện Quảng Xương, trong 30 ngày qua bệnh nhân không đi đâu khỏi địa phương. Nguồn nước sinh hoạt chủ yếu của gia đình từ nước giếng khoan. Gia đình bệnh nhân ở khu nhà khép kín, không chăn nuôi, không làm nông nghiệp; bệnh nhân cũng không có các vết trầy xước trên da.
Theo người nhà bệnh nhân, từ ngày 22/8 đến 30/8/2023, bệnh nhân bị đau họng, ho, sốt cao, uống nhiều nước, sụt cân (7kg/10 ngày), bệnh nhân tự mua thuốc điều trị tại nhà nhưng không đỡ.
Ngày 1/9/2023 gia đình đưa bệnh nhân đến Phòng khám An Phúc ở xã Tiên Trang khám và lấy thuốc theo đơn về điều trị, nhưng bệnh vẫn diễn biến ngày càng nặng nên được đưa đến Bệnh viện 71 TW khám và điều trị rồi được chuyển đến Bệnh viện Nhi Thanh Hóa trong tình trạng hôn mê.
Trung tâm Y tế huyện Quảng Xương đã phân tích nguy cơ và các biện pháp phòng chống bệnh Whitmore; giám sát các trường hợp liên quan, vệ sinh môi trường khu vực xung quanh nhà bệnh nhân; đưa các trường hợp nghi ngờ bị mắc bệnh đến ngay các cơ sở y tế khám và điều trị.
Trước đó, tháng 11/2022, tại Thanh Hóa cũng đã phát hiện 2 bệnh nhân mắc Whitmore, trong đó bệnh nhân 15 tuổi (ở thị xã Nghi Sơn) đã tử vong do suy đa tạng, sốc nhiễm khuẩn, hoại tử ruột.
Theo Cục Y tế dự phòng (Bộ Y tế), bệnh Whitmore là bệnh nhiễm trùng ở người và động vật do vi khuẩn Burkholderia Pseudomalle gây ra.
Vi khuẩn B. pseudomallei sống trong đất, nước bị nhiễm khuẩn và xâm nhập vào cơ thể chủ yếu qua da khi có vết thương hở tiếp xúc trực tiếp với đất, nước bị nhiễm khuẩn B. pseudomallei.
Hiện chưa có bằng chứng về việc lây truyền vi khuẩn từ người sang người hoặc từ động vật sang người. Cũng chưa có vắc xin phòng bệnh Whitmore.
Bệnh Whitmore là bệnh không thường gặp, không lây lan thành dịch. Nhưng bệnh có biểu hiện lâm sàng rất đa dạng, khó chẩn đoán và có thể tử vong nếu không được chẩn đoán và điều trị kịp thời, đặc biệt ở những người có bệnh nền như tiểu đường, bệnh gan, thận, phổi mạn tính, suy giảm miễn dịch ...
Cục Y tế dự phòng khuyến cáo cách phòng bệnh Melioidosis (Whitmore):
Hạn chế tiếp xúc với đất hoặc nước bùn, đặc biệt là những nơi bị ô nhiễm nặng.
Sử dụng giày, dép và găng tay đối với những người thường xuyên việc ngoài trời, tiếp xúc với đất và nước bẩn, đặc biệt đối với những người có nguy cơ cao.
Khi có vết thương hở, vết loét hoặc vết bỏng cần tránh tiếp xúc với đất hoặc nước có khả năng bị ô nhiễm. Nếu bắt buộc phải tiếp xúc thì sử dụng băng chống thấm và cần được rửa sạch đảm bảo vệ sinh.
Những người có bệnh mãn tính như tiểu đường, suy giảm miễn dịch cần được chăm sóc, bảo vệ các tổn thương để ngăn ngừa nhiễm khuẩn.
Khi nghi ngờ nhiễm bệnh cần đến cơ sở y tế để được tư vấn, khám phát hiện, xét nghiệm xác định nhiễm vi khuẩn B. pseudomallei và điều trị kịp thời.
























